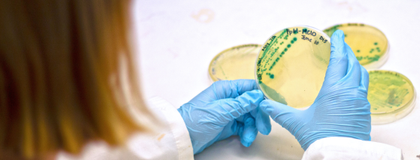
student looks at bacteria on petri dish

Microbiology
Why Study Microbiology at U of G?
Microbiology is the scientific study of microorganisms, living entities that are too small to be seen by the naked eye, such as bacteria, viruses, and fungi.
The impact and importance of microbiology has never been more apparent than it is today. The field has application in a variety of fields, including medicine and human health; the environment and climate change; and agriculture, food and biotechnology.
Learn from award-winning faculty making groundbreaking discoveries in antimicrobial resistance, microbiome health, neurodegenerative diseases, food security and sustainability, and genetic engineering, among many other research strengths.
Gain a Breadth of Microbiology Knowledge
Study diverse microorganisms such as bacteria, viruses and fungi, and understand their relevance in medicine, biotechnology, food production and the environment. Broad training is offered in the areas of cell biology, immunology, biochemistry, molecular biology, genetics, bioinformatics and biotechnology.
Access Top-Tier Research Labs
The Microbiology program is lab-intensive, allowing students to develop hands-on skills that will be beneficial in future scientific careers. Fourth-year students can take research project courses, where they will work in the laboratory of a professor to learn cutting-edge techniques applied to exciting areas in microbiology.
Gain Hands-on Experience Through Co-op
Students in the co-op program gain valuable work experience while earning their degree. Previous co-op employers include pharmaceutical companies, hospitals, agri-food and supply companies, and government and academic labs.
To see all courses offered in the Microbiology program, visit our Academic Calendar.
- Top Comprehensive University
- in Canada (Maclean’s 2025)
- Top 150 in the World
- for Life Sciences (Times Higher Education 2025)
- Top 20% in the World
- for Biological Sciences (QS World University Rankings by Subject 2025)
- Top 4 in Canada
- for Microbiology (EduRank 2025)

Careers in Microbiology
Microbiology students learn a broad range of molecular biology, genetics, and bioinformatic skills that are highly sought after by employers in both the public and private sectors. This integrated training in the biological sciences prepares students for a broad range of careers in science and further education.
Here are a few careers our graduates have successfully pursued:
- Research Technician
- Pediatric Gastroenterologist
- Medical Associate
- Research Analyst
- Bioinformatician
- Physician
Gain Valuable Experience Through Co-op
The Microbiology co-op is a five-year program that includes four paid work terms. Apply what you’ve learned in the classroom to the real world, with hands-on work experiences available in private, non-profit, and governmental organizations. Benefits of co-op include:
- Relevant work experience
- Up to 16 months of work experience
- Earning while learning
- Career exploration
- Professional networking
Students can apply for the co-op program directly from high school or later for in-course admission. Learn more about the Microbiology co-op program.
- Associate Analyst
- Bioprocessing Intern
- Co-op Student - Vaccines
- Food Safety Inspector
- Laboratory Technologist
- Molecular Biology Researcher
- Production and Laboratory Assistant
- Production Support Analyst
- Quality Assurance Technician
- Quality Control Assistant
- Research and Development Assistant
- Research Assistant
Hear From Microbiology Students and Graduates
Discover More Options
Students considering Microbiology may also be interested in Animal Biology, Ecology, Wildlife Biology and Conservation, Zoology, or other majors.
Admission Requirements
Explore admission requirements for Canadian, international, transfer, and mature students. Start your journey today!
Scholarships & Bursaries
We offer a wide range of financial aid programs to assist with funding your education at the University of Guelph.
Tour Our Campus
Through virtual tours, presentations, webinars and in-person tours, get familiar with the University of Guelph campus.
Have Questions?
Learn more about how to connect, discover, and engage with programs, facilities and life at the University of Guelph.





